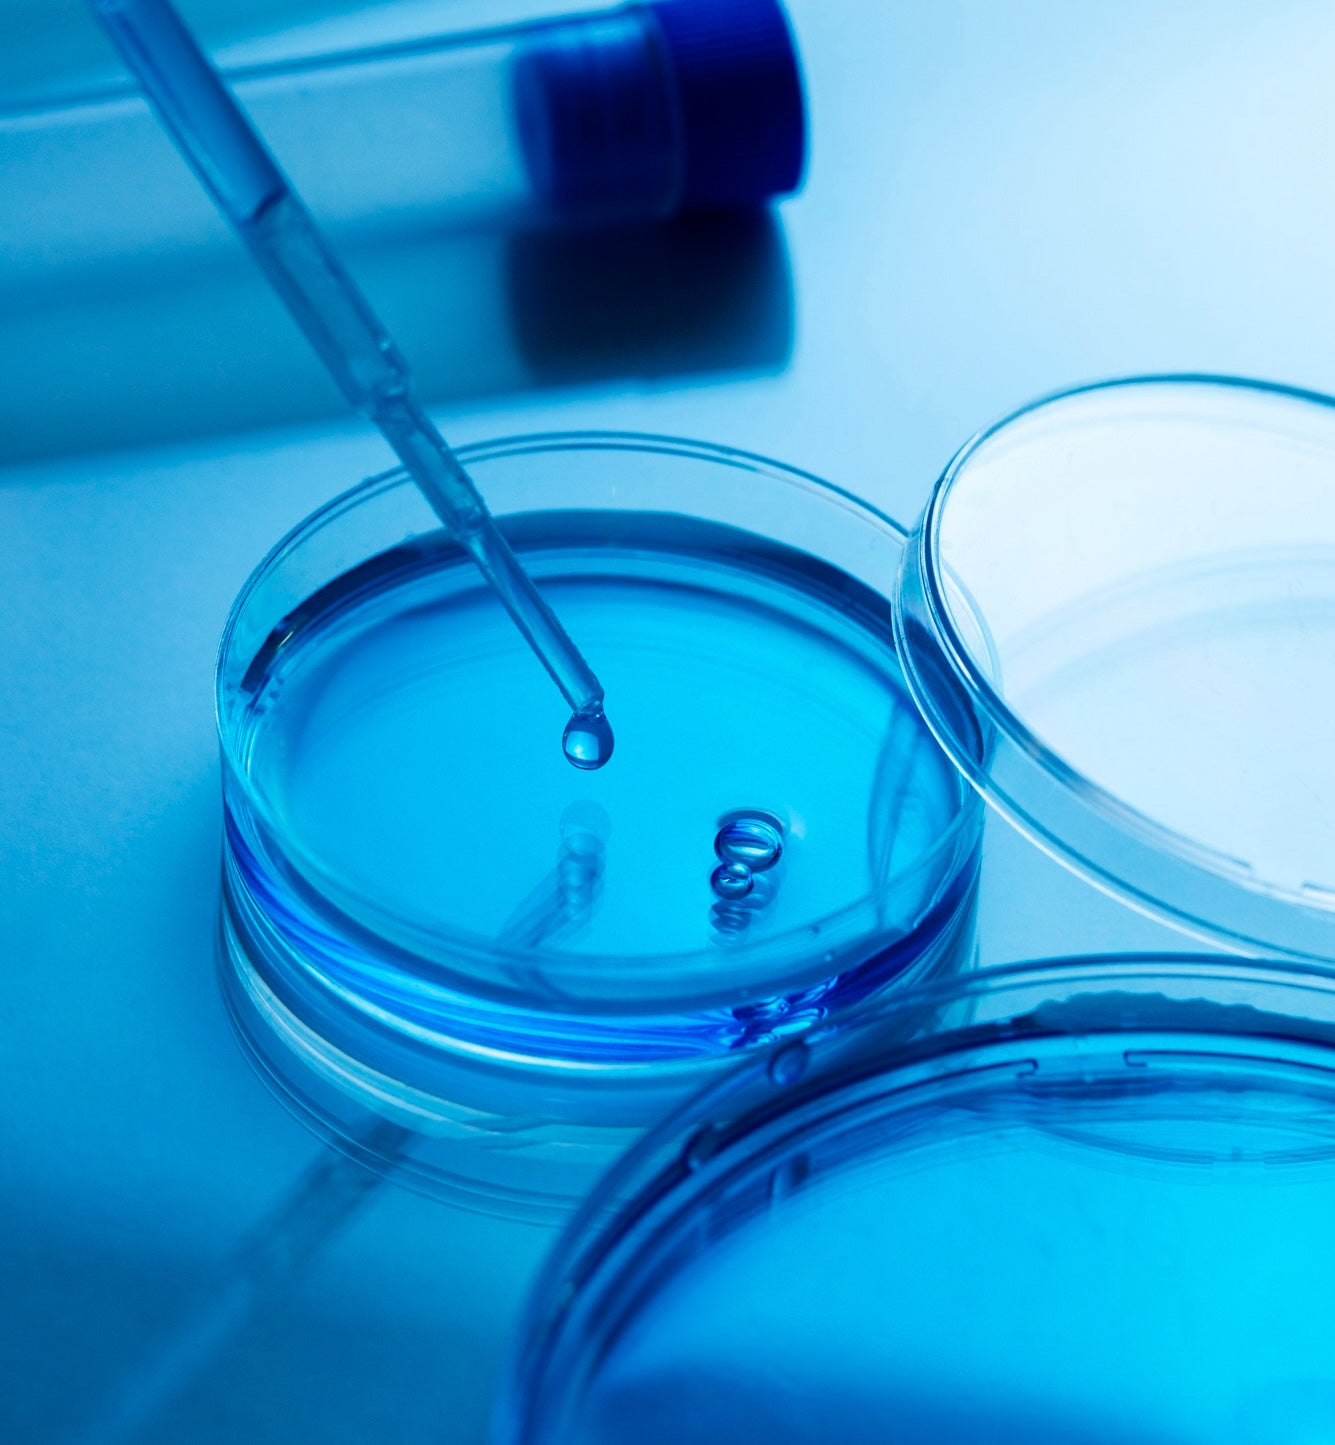

CARLOS TOKYOについて
CARLOS TOKYOは、働き盛りの男性を根本から支えていくための高品質なメンズコスメブランドです。
CARLOS TOKYOの製品は、日々のスキンケアを格上げし、自信に満ちた輝く肌を実現するために研究・設計されています。
健康的で清潔感のある肌は紳士としての信頼性や魅力を高め、ビジネスやプライベートでの第一印象を格段にアップさせます。
肌の老化を防ぎ若々しい印象を長く保つことで、魅力を向上させ、積極的な行動や挑戦にも繋がります。
CARLOS TOKYOの製品で、あなたも自信に満ちた素肌を手に入れ、日々の生活に新たな輝きを加えてください。
世界の知識を、一点に
CARLOS TOKYOのポイント
CARLOS TOKYOの製品は、経験豊富な調合士によって調合されたこだわりのレシピから丁寧に調整されています。
最先端※の技術と厳選された成分を使用し、肌に優しく、それでいて確かな効果を実感できる製品を提供します。
ただの基礎化粧品ではなく、あなたのライフスタイルをより豊かにするためのパートナーを目指します。
※CARLOS TOKYOシリーズ内において

高品質成分
CARLOS TOKYOの製品に含まれる一部成分のご紹介。
- ヒト幹細胞培養液…たんぱく質を含んだ成分で、ハリのあるみずみずしい肌へ整えます。年齢肌の悩みに対応する次世代のエイジングケア美容成分です。
- エクソソーム…コラーゲンやエラスチンの生成をサポートし、肌にハリと弾力を与えます。ヒト幹細胞培養液と併用することで、相乗効果が期待できる美容成分です。
- グリコール酸(AHA)…フルーツ酸の一種で、サトウキビやパイナップルなどの果物に多く含まれている天然由来成分です。デイリーピーリングとして、肌の表面を整え、ざらつき、ごわつきを和らげます。
- 浸透型ペプチドビタミンC誘導体…肌の透明感をアップし、ハリと弾力をサポートする成分です。ビタミンCにペプチドを結合させることで安定化し、ナノ化技術によって浸透性を高めています。
※配合される成分は製品によって異なります。詳しくは製品詳細ページをご確認ください。
革新的な技術
CARLOS TOKYOは世界中の美容製品を自らの目で見て、自身の肌で試し、本当に効果・効能のある技術のみを厳選して採用しています。その中でも特に注目しているのがナノ化技術です。
ナノ化技術について
ナノ化技術とは、顕微鏡で見える世界よりもさらに小さなナノメートル単位の世界で物質を研究開発するための先端技術です。この技術を用いることで、美容成分の粒子を非常に小さくすることが可能になり、肌への浸透力が格段に高まります。これにより、美容成分が肌の奥深くまで届き、その効果を最大限に発揮します。
なぜナノ化技術を採用するのか
- 浸透力の向上: 微細化された成分は、肌のバリアをよりスムーズに通過し、深層まで行き渡ります。これにより、成分の効果をより直接的に、迅速に感じることができます。
- 成分の安定性: ナノ化技術を使用することで、美容成分の安定性が向上し、劣化しにくくなります。これにより、製品の品質を長期間保つことができます。
- 均一な分散: ナノ化された成分は、肌に均一に分散しやすく、ムラのない美しい仕上がりを実現します。
- 高濃度での配合: 微細化されることで、より高濃度の美容成分を配合することが可能になり、効果を一層高めます。

効果実証
CARLOS TOKYOの製品は、実際の効果が証明された根拠に基づいて作られています。世界30カ国を巡り、各地の美容製品を試し、その効果を実感した成分と技術のみを採用しています。
実験段階から多くの高い評価を受けています。※
- 40代 男性:「男性が朝夜のスキンケアをするというのには驚きましたが、肌のハリが格段にアップし、キメが整い、印象が若く見えると言われることが多くなり、毎日のスキンケアが楽しみになりました。」
- 30代 男性:「元々肌のバランスが悪いのか乾燥肌に悩んでいましたが、CARLOS TOKYOの商品を使い始めたところ、乾燥肌が改善してきたように思います。もう手放せません。」
- 50代 男性:「シワやたるみが気になっていましたが、CARLOS TOKYOの美容液を使用し始めたところ、翌日からハリを感じ、継続使用することで肌が若々しくなり、自信が持てるようになりました。」
- 20代 男性:「特にニキビ跡や毛穴の開きが気になっていたのですが、使い続けるうちに肌の調子が良くなり、友達からも褒められることが増えました。」
私たちは、製品の効果を常にモニタリングし、ユーザーのフィードバックを基に改善を重ねています。これにより、常に最高品質の製品を提供し続けることができます。
CARLOS TOKYOの製品は、単なるスキンケアではなく、実際に効果を実感できるブランドです。ぜひ、その違いをお試しください。
※あくまで個人の感想であり、実際の効果を証明するものではありません

熟練の調合士
CARLOS TOKYOの開発の裏には、経験豊富な調合士たちの存在があります。製品の開発から製造までのすべての工程で重要な役割を果たしています。
調合士とは?
調合士とは、化粧品の成分を選定し、最適な配合比率を見つけ出す専門家です。化粧品の効果と安全性を最大限に引き出すために、科学的な知識と技術を駆使して製品を作り上げます。
CARLOS TOKYOの調合士
- 豊富な経験と知識:長年にわたる経験を持ち、化粧品成分に関する深い知識を持っています。これにより、最新の美容成分と技術を取り入れた製品を開発することができます。さらに、世界で発見されたことのない新しい成分を発見し、それを国際的な規制機関や特許機関に登録する活動も行っています。
- 厳選された素材:世界中から厳選された高品質の成分を使用し、その特性を最大限に引き出す配合を行います。
- 科学的アプローチ:成分の効果を科学的に検証し、安全性を確認した上で製品化します。これにより、信頼性の高い製品を提供しています。
- 革新と創造:常に新しい成分や技術を探求し、革新的な製品を生み出す努力を惜しみません。
調合士の専門知識と情熱が、CARLOS TOKYOの製品に命を吹き込み、皆様の肌に自信と輝きをもたらします。努力とこだわりが詰まった製品を、ぜひお試しください。



